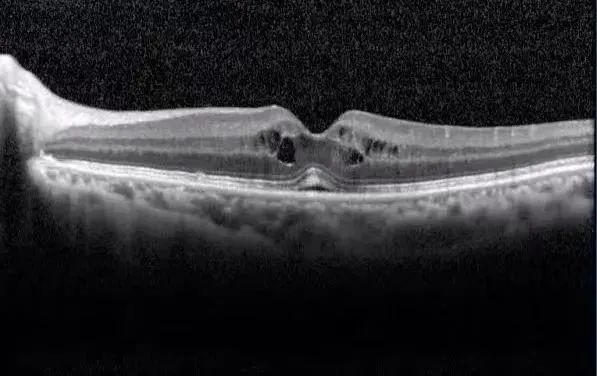
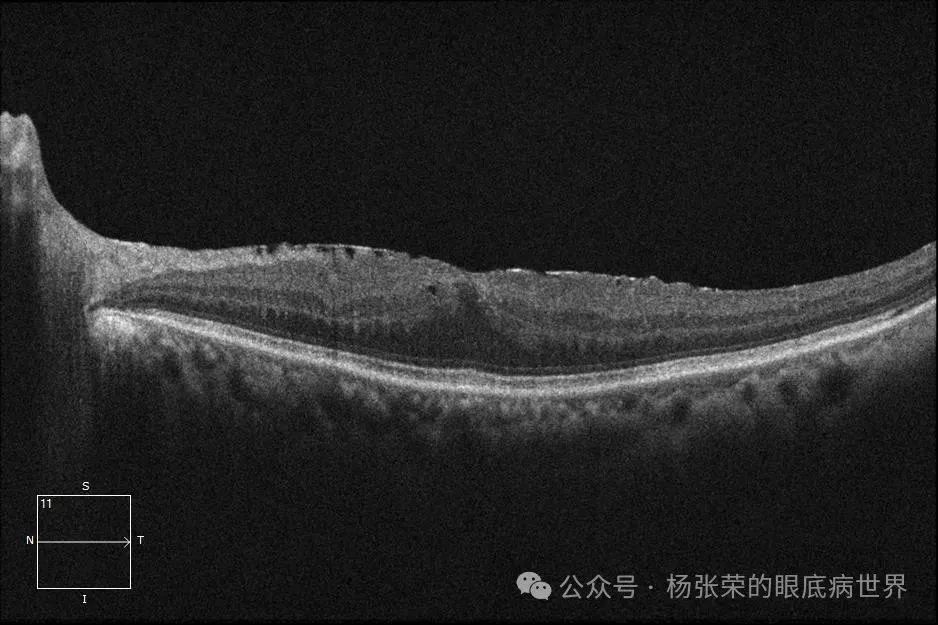

我们在临床上每天可以看到黄斑水肿,常表现为视力下降、视物变形或视物遮挡。随着抗血管内皮生长因子 (VEGF)时代的到来,黄斑水肿的患者大量涌入我们的视线,下面我们来看看这例病人。
病例情况
患者,女性,85岁;主 诉:双眼视物模糊3天于2024.7.9就诊于我院。既往史:2024.4.25行左眼P+I,2024.5.22行右眼P+I,类风湿关节炎20年,现未治疗,无高血压、糖尿病病史。
眼科检查:BCVA VOD 0.3 OS 0.1,IOP R11mmHg L 12mmHg,双眼前节(-),玻璃体未见细胞,双眼黄斑区水肿。


OCT:右眼黄斑囊样水肿,左眼黄斑囊样水肿,黄斑前膜


翻阅患者白内障术前眼底OCT:双眼黄斑未见明显水肿,左眼黄斑前膜


白内障术后一月复查:BCVA VOD 1.0 OS 0.6,IOP R11mmHg L 12mmHg,双眼前节(-),玻璃体未见细胞,双眼黄斑区未见水肿。
寻因问果
这例病人在白内障术后右眼2个多月,左眼1个多月出现了双眼黄斑水肿,那他是什么原因导致的水肿?该怎么治疗呢?
根据病史及体征答案呼之欲出:
-
诊断:
1. 双眼Irvine-Gass综合征;
2. 双眼人工晶体植入状态;
3. 左眼黄斑前膜
白内障术后黄斑囊样水肿
-
定义
指白内障术后出现黄斑囊样水肿,血-视网膜屏障(BRB)破坏后液体在黄斑区视网膜内积聚,常出现于白内障术后4-6周,又称为人工晶状体性黄斑水肿(PCME)。
-
发病机制
白内障手术操作引起的机械性损伤以及人工晶体异物反应、晶状体上皮残留等等,使房水内促炎性因子(前列腺素)和促血管生成因子水平增加。
炎性因子刺激,造成血-视网膜屏障的破坏,渗漏增加。屏障破坏、渗漏增加以及炎性因子等一系列影响,造影时出现视盘晚期高荧光渗漏,表明白内障术后黄斑水肿属于术后炎性反应的一种类型。

-
危险因素
包括高血压、糖尿病、自身免疫相关性疾病等全身疾病以及葡萄膜炎、视网膜前膜、玻璃体视网膜牵拉等眼部疾病。
-
分类
无症状:OCT检查发现形态学的改变,但视力不受影响。
临床型:伴视力的下降
临床型分期:
①急性:3个月内,大多发生在术后4-12周
②慢性:持续6个月
③迟发:术后3个月后发生
-
临床表现
白内障术后一段时间出现无痛性视力下降,伴或不伴视物变形。眼底检查黄斑中心凹反光消失、黄斑囊样水肿。
FFA:早期中心凹旁毛细血管渗漏着染,晚期呈典型的星状、花瓣状荧光蓄积,可伴有视盘渗漏

OCT:黄斑弥漫水肿或囊样水肿,视网膜内囊样水肿首先发生于内核层,然后向外从状层扩散,最终可见液体在视网膜下,而视网膜外层结构破快并不严重
enfaceOCT:黄斑水肿处呈蜂巢样改变

-
治疗
-
治疗原发疾病。
-
停用肾上腺素、地匹福林和前列腺素衍生物滴眼液和含烟酸药物。极少情况下,利尿药和口服避孕药可诱发非典型黄斑囊样水肿,停药后可自行缓解。
-
非甾体抗炎药物滴眼 [NSAIDs,双氯芬酸(Voltaren)或酮咯酸(Acular)1 天 4 次 ] 和(或)激素滴眼(1% 醋酸泼尼松龙 1 天 4 次,使用 1 个月,缓慢减量)。1 项随机研究显示,NSAIDs 和激素滴眼液联合治疗比单独治疗更有效。
-
对滴眼液治疗无效者可考虑后 Tenon 囊下注射激素(曲安奈德 40mg/ml)。
-
如仍无效,可考虑口服 NSAIDs 药物(吲哚美辛,25mg,1 日 3 次,持续 6 ~8 周),口服激素(泼尼松龙40~60mg,1 天 1 次,持续 1 ~ 2 周,然后逐渐减量)和(或)口服乙酰唑胺(250mg,1 天 2 次)。以上治疗方法未经验证。
-
慢性PCME可考虑玻璃体腔注射糖皮质激素(Ozurdex)
-
预后
一般较好。数周到数月内自行消退(术后),慢性黄斑囊样水肿(> 6 个月)预后较差,可能发生黄斑裂孔。
治疗及随诊
-
治疗方案
双眼球后注射曲安奈德注射液20mg,普拉洛芬滴眼液,点双眼 4次/日。
-
治疗14天后复查
BCVA VOD 0.3 OS 0.4,IOP R11mmHg L 12mmHg,双眼前节(-),玻璃体未见细胞,右眼黄斑区水肿,左眼黄斑区未见水肿,可见前膜。

总结
黄斑水肿(ME)的病理生理较为复杂,主要结构改变是血-视网膜屏障的破坏,视网膜静脉阻塞、糖尿病、葡萄膜炎、手术以及一些药物均可继发ME。
不同病因导致的ME发病机制不同,其中血管内皮生长因子 (VEGF)和炎症为主要的致病途径。
抗VEGF药物针对眼底血管类疾病引起的ME疗效甚佳,但尚当发病机制为炎症时,如何在局部或全身、激素或非甾体类消炎药等诸多治疗措施中选择适合患者的个性化方案成为治疗的难点。
同时,加强对高危人群的宣传教育、积极开展筛查工作并做好预防,亦是当前的重点。当我们接诊病人时,只有深入理解ME的发病机制及病理生理,全面了解其不同病因及危险因素,熟练掌握当前不同治疗措施的适应证及优缺点,才能准确诊断、精准治疗,为患者提供个性化的治疗和随访方案。
声明:本文转载于<e讯视界>,以上仅代表作者本人观点,仅用于学习交流,版权归原作者所有。








